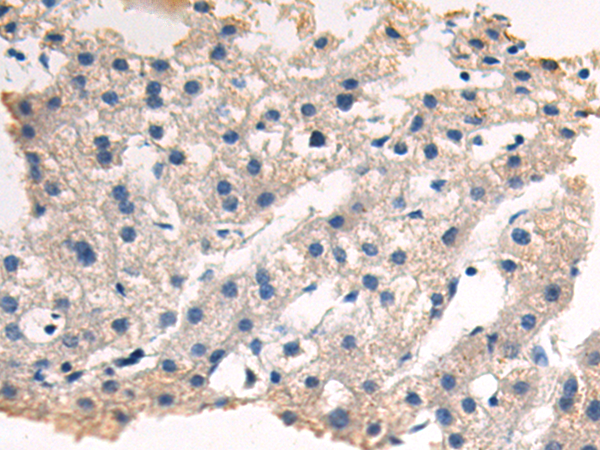
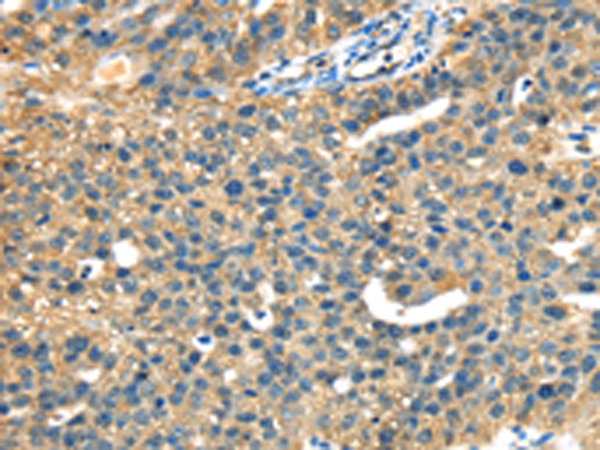
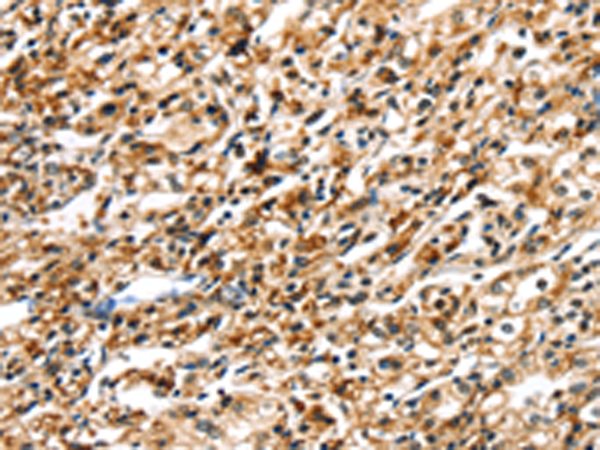

-
分类: 科研抗体货号: P08731别名: p6; CAGC; CGRP; MRP6; CAAF1; MRP-6; ENRAGE应用: IHC反应种属: Human
-
分类: 科研抗体货号: P08730别名: MLN70; S100C; HEL-S-43应用: WB,IHC反应种属: Human, Mouse, Rat
-
分类: 科研抗体货号: P08749别名: SeP; SELP; SEPP; SEPP1应用: WB,IHC反应种属: Human
-
分类: 科研抗体货号: P08727别名: TC21应用: WB反应种属: Human, Mouse
-
分类: 科研抗体货号: P08769别名: SFRSK1应用: IHC反应种属: Human, Mouse
-
分类: 科研抗体货号: P08748别名: DCE; SELADIN1; Nbla03646; seladin-1应用: WB,IHC反应种属: Human, Mouse, Rat
-
分类: 科研抗体货号: P08758别名: CAP; PI6; PTI; PI-6; SPI3; DFNB91; MSTP057应用: IHC反应种属: Human
-
分类: 科研抗体货号: P08767别名: S2V; SLG; SIGLECL1; Siglec-XII应用: WB,IHC反应种属: Human, Mouse
-
分类: 科研抗体货号: P08746别名: FP; PGL5; SDH1; SDH2; SDHF; CMD1GG应用: WB,IHC反应种属: Human, Mouse, Rat
-
分类: 科研抗体货号: P08757别名: OL-64应用: IHC反应种属: Human

鄂公网安备42018502007531号
鄂公网安备42018502007531号

